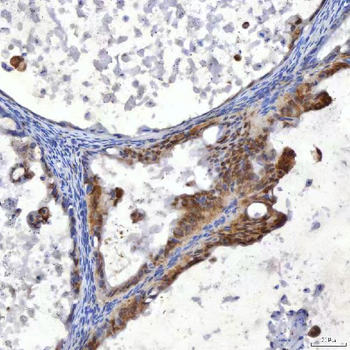
SUMF2 Rabbit Polyclonal Antibody

You have no items in your shopping cart.
All Products
- Featured
UGT1A1 antibody [orb247293]Featured
ICC, IF, IHC-P, WB
Guinea pig, Human, Mouse, Porcine, Rat
Rabbit
Polyclonal
Unconjugated
100 μg - Featured
GAS6 antibody [orb389646]Featured
ICC, IF, IHC-P, WB
Guinea pig, Human, Mouse, Porcine, Rat
Rabbit
Polyclonal
Unconjugated
200 μg, 100 μg - PCDH15 Rabbit Polyclonal Antibody [orb526999]
FC, ICC, IHC, IHC-Fr, WB
Human, Mouse, Rat
Rabbit
Polyclonal
Unconjugated
100 μg - CD147/Emmprin Mouse Monoclonal Antibody [orb1145849]
FC, IF, IHC, WB
Human, Mouse
Mouse
Monoclonal
Unconjugated
100 μg - HGS Mouse Monoclonal Antibody [orb1145858]
FC, ICC, IF, IHC, WB
Human, Mouse, Rat
Mouse
Monoclonal
Unconjugated
100 μg - Histone H1.0/H1F0/H1 Mouse Monoclonal Antibody [orb1145786]
FC, IHC, WB
Human, Mouse
Mouse
Monoclonal
Unconjugated
100 μg - FEN1 Mouse Monoclonal Antibody [orb1145864]
FC, ICC, IF, IHC, WB
Human, Mouse, Rat
Mouse
Monoclonal
Unconjugated
100 μg - AHA1/AHSA1 Rabbit Polyclonal Antibody [orb1145840]
ELISA, FC, ICC, IF, IHC, WB
Human, Mouse, Rat
Rabbit
Polyclonal
Unconjugated
100 μg - ENO1 Rabbit Polyclonal Antibody [orb1145817]
ELISA, FC, IHC, WB
Human
Rabbit
Polyclonal
Unconjugated
100 μg - SUMF2 Rabbit Polyclonal Antibody [orb1676533]
ELISA, FC, IF, IHC, WB
Human
Rabbit
Polyclonal
Unconjugated
100 μg